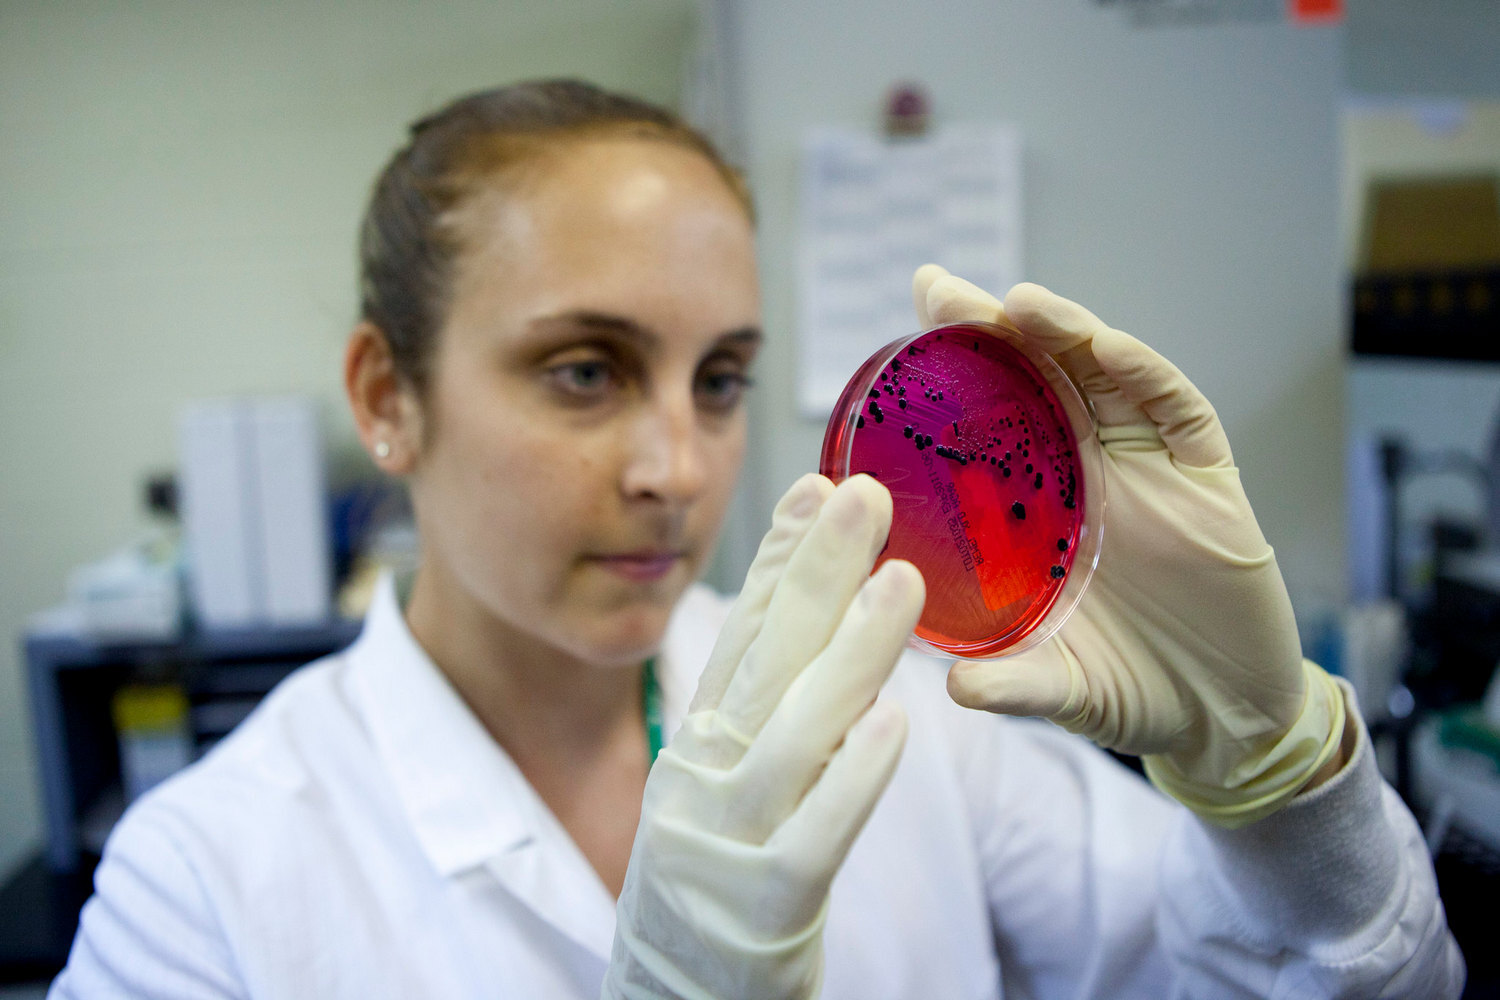

В Петербурге — два массовых отравления сальмонеллой. Почему это не эпидемия
В сентябре сотни петербуржцев отравились готовой едой — в школе № 608 в Кировском районе и через блюда от Greenbox, доставленные сервисом «Самокат». Согласно заявлениям Роспотребнадзора, у пострадавших врачи обнаружили сальмонеллу — бактерию, которая вызывает острую кишечную инфекцию.
«Бумага» рассказывает, что известно об отравлениях, как сальмонелла могла попасть на пищевые предприятия и как можно себя обезопасить.
Что известно об отравлениях через доставку и в школе?
На прошлой неделе в Петербурге два раза фиксировали массовые случаи отравления — сперва из-за блюд в школьной столовой, а затем из-за доставки еды от кафе Greenbox.
7 сентября стало известно о появлении очага острой кишечной инфекции в школе № 608 имени Зины Портновой Кировского района. Отравились минимум 56 учеников и сотрудников, некоторые оказались в реанимации. У части детей обнаружили сальмонеллу, сообщал Роспотребнадзор.
В пищевом блоке школы выявили нарушения санитарно-эпидемиологических требований:
- Нет условий для соблюдения учащимися и сотрудниками правил личной гигиены.
- В блоке не проводят дезинсекцию.
- Обнаружены синантропные насекомые.
9 сентября петербуржцы массово отравились готовой едой, заказанной через доставку «Самокат» в кафе Greenbox. На данный момент известно о 248 случаях болезни, в том числе у двух детей. В продукции обнаружили сальмонеллу, также бактерию нашли у восьми заболевших.
Какие нарушения нашли на производстве Greenbox:
- Правила приготовления блюд нарушались.
- Продукты хранили с нарушениями условий, реализации и сроков годности, условий хранения.
- Сотрудники не проходили медосмотры.
- Помещения не были достаточно убраны.
По данным «Бумаги», отравившиеся едой из Greenbox покупали шпинатную вафлю с яйцом, ветчиной и голландским соусом. То же самое рассказали пострадавшие «Фонтанке».
Какие меры приняли власти из-за отравлений и как реагируют компании?
После массового отравления детей школу в Кировском районе Петербурге на время закрыли. Как сообщал «78 канал» со ссылкой на источники, отравление могло произойти из-за возбудителей сальмонеллеза. Некачественная еда могла попасть в школьную столовую через поставщика — комбинат питания «Кировский».
По факту обоих инцидентов — в кафе и в учебном заведении — следственный комитет возбудил уголовные дела об оказании услуг, не отвечающих требованиям безопасности жизни или здоровья потребителей (ч. 1 ст. 238 УК РФ).
В отношении Greenbox в Роспотребнадзоре составили протокол о временном запрете деятельности. Из меню «Самоката» исчезла продукция кафе Greenbox. Сервис доставки заявил о том, что начато внутреннее расследование условий хранения и транспортировки.
Роспотребнадзор сообщил о готовности содействовать пострадавшим в составлении досудебной претензии к компаниям «Грин Бокс» и «Умный Ритейл» (бренд «Самокат»).
Как рассказали «Бумаге» пострадавшие, которые объединились для защиты прав, в Greenbox им согласились полностью оплатить лечение от отравления, а также дополнительные медицинские обследования. Петербуржцы также рассчитывают на компенсацию морального вреда и планируют подать коллективный иск к компании.
В каких продуктах распространяется сальмонелла и возможно ли распознать бактерию?
По словам доктора медицинских наук и профессора кафедры инфекционных болезней и эпидемиологии РНИМУ им. Н. И. Пирогова Владимира Никифорова, сальмонелла — это бактерия, которая «тяготеет к молоку, мясу, курице и яйцам». Однако к передаче инфекции могут быть причастны и другие продукты, включая загрязненные навозом овощи.
«Это довольно широко распространенная бактерия. Ее носителями могут быть как животные, так и люди. Например, курицы могут сами не болеть, но быть переносчиком, из-за этого сальмонелла может содержаться в яйцах, например. При этом по виду невозможно определить, что в еде сальмонелла, она будет выглядеть качественной: не будет тухлого запаха и кислого вкуса», — сказал Никифоров.
Инфекционист отмечает, что из-за неправильных условий хранения — например, разморозки и повторной заморозки — может увеличиться содержание сальмонеллы в продукте. Однако если носителей бактерии или зараженных продуктов изначально нет на пищевом предприятии, то из-за некачественного хранения она не возникнет.
С чем могут быть связаны случаи заражения? И как себя обезопасить?
По предположению Владимира Никифорова, заражение сальмонеллой могло произойти, если яйца в вафлях из кафе Greenbox не прошли достаточную термическую обработку. «При качественной термической обработке сальмонелла не грозит. Прогрев до 100 градусов (часто для варки яиц достаточно и 70 градусов — прим. «Бумаги») гарантированно уничтожает бактерию», — говорит он.
Также плохая термическая обработка продуктов для школьной столовой или кафе могло стать причиной появления очага инфекции. «На предприятие могло попасть не прошедшее ветеринарный контроль мясо, в котором была сальмонелла. Если термически это мясо не обработали, сальмонелла в нем могла прекрасно расти, а дальше пошло заражение других продуктов», — считает инфекционист Владимир Никифоров.
Еще одной причиной массового отравления, по мнению профессора, мог стать инфицированный сотрудник-носитель сальмонеллы, который не соблюдает правила личной гигиены. Как уточняется на сайте ВОЗ, передача инфекции от человека происходит фекально-оральным путем.
Всемирная организация здравоохранения рекомендует следующие меры профилактики: следить за тем, чтобы еда животного происхождения прошла тщательную тепловую обработку, и мыть руки с мылом. Если есть сомнения в безопасности воды или продуктов, их можно прокипятить или разогреть.
Можно ли самому лечить инфекцию и насколько сальмонеллез опасен?
На сайте Всемирной организации здравоохранения отмечается, что для сальмонеллеза — болезни, вызываемой бактерией Salmonella — характерны резкое повышение температуры, боль в области живота, диарея, тошнота и иногда рвота. Симптомы обычно появляются через 12-36 часов после приема еды с сальмонеллой, а сама болезнь длится от 2 до 7 дней.
Особо опасно, по данным ВОЗ, заражение сальмонеллой для детей и пожилых пациентов — связанное с болезнью обезвоживание может становиться тяжелым и представлять угрозу для жизни. Однако в большинстве случае симптомы протекают относительно легко, а пациенты выздоравливают без специального лечения.
«Если при отравлении из-за продуктов с сальмонеллой температура невысокая, можно несколько часов попробовать отлежаться, пить воду, но не пытаться остановить симптомы. Вместе с диареей и рвотой выходит возбудитель и токсин, — добавляет инфекционист Владимир Никифоров. — Если симптомы длятся несколько часов, то стоит вызвать скорую. Несмотря на то, что сальмонеллез может привести к осложнениям вплоть до летальных исходов, в XXI веке вряд ли кто-то умрет: мы хорошо знаем клинику и патогенез, умеем это лечить».
Когда в Петербурге в последний раз была вспышка сальмонеллеза? И от чего это зависит?
Осенью 2022 года в Петербурге также фиксировали массовое отравление сальмонеллой (и золотистым стафилококком) — тогда компания «Клипперс» обеспечивала некачественным питанием сотрудников строительной компании «Прайдекс Констракшн». В больнице оказались 27 человек, а уголовное дело против поставщика питания в итоге прекратили.
Судя по сообщениям в СМИ, сальмонеллез в Петербурге фиксируют ежегодно. По данным ВОЗ, от 60 до 80 % всех случаев заболевания вовсе не регистрируются.
Как отмечает инфекционист Владимир Никифоров, на вспышки сальмонеллеза вряд ли влияет сезон. Он связывает новые случаи отравления тем, что некоторые предприятия не соблюдают нормы СанПиН.
Что еще почитать:
- Нехватка лекарств и рост цен в 1,5 раза. Рассказываем, как год войны повлиял на онкопомощь в Петербурге и как реагируют власти.
- Всё меньше производят лекарства и автомобили, всё чаще болеют гриппом. Что интересного показала статистика за 2022-й.